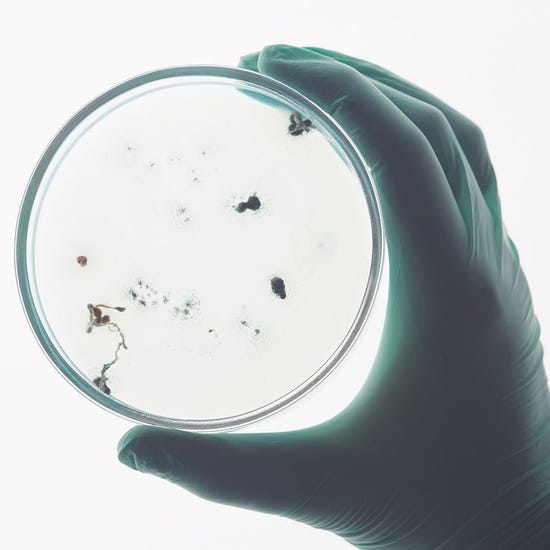

Tu guía sobre los gérmenes y enfermedades y cómo protegerte y a tu familia de ellos.
Tenemos más de 100 años protegiendo a las personas de gérmenes y de trabajar con los profesionales médicos. Hemos aprendido bastante acerca de las enfermedades y de cómo protegerte y a tus seres queridos. Hemos conjuntado esta experiencia en una guía integral que ayudará a que tus seres queridos y tú se mantengan sanos.

¿En qué se diferencia el resfriado común y la gripa?
Conoce los síntomas de un resfriado común y de la gripa, cómo se diferencian y la forma adecuada para protegerte a ti y a tu familia.

¿Qué es la gripe aviar?
Conoce más acerca de la gripe aviar que no solo afecta a los humanos, sino también a los animales.
.jpeg?width=550&height=122&format=jpg&quality=80)
¿Qué tanto sabes de la diarrea?
Te compartimos información relevante acerca de una de las enfermedades más comúnes: la diarrea.

¿Cómo evitar la intoxicación por alimentos?
Algunos alimentos contienen gérmenes que se propagan fácilmente. Te guíamos en cómo evitarlo.

Evita la tifoidea con higiene y limpieza
La fiebre tifoidea es una infección bacteriana que puede afectar a varios órganos del cuerpo. Te compartimos las causas, síntomas y cómo evitarla.



Prevé la Gripe porcina o Influenza (H1N1)
El riesgo de gripe porcina continúa, la Influenza H1N1 es una de las principales cepas de la gripe que sigue circulando. Aquí te enseñamos como prevenirla.

Las enfermedades podrían ser causadas por gérmenes, como el virus causante de la influenza y gripe, que pueden estar hasta donde menos te imaginas.
Las enfermedades podrían ser causadas por gérmenes, como el virus causante de la influenza y gripe, que pueden estar hasta donde menos te imaginas.

¿Qué son los gérmenes y cómo se propagan?
Conoce más acerca de los gérmenes, los cuales son organismos microscópicos que pueden causar enfermedades e infecciones si entran en nuestro cuerpo.

¿Por qué nos enfermamos de gripe e influenza?
La respuesta te sorprenderá

